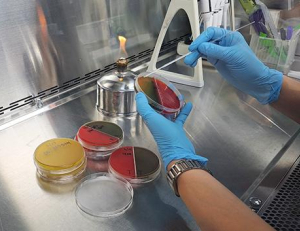
기사이미지

Top
-
- 전남도 '공익직접지불금' 신청 누락 사각지대 해소한다
- 전남지역 공익직접지불금 신청건수가 증가 추세로 나타난 가운데 전남도가 서류 미비로 신청 누락 사각지대 해소 등을 위해 현장 점검에 나선다.
전남도는 농업농촌의 공익기능 증진과 농업인 소득 안...
- 2023-07-05

- 여수해수청, 260억원 들여 여수 낭도항 정비
-
여수시 화정면 낭도의 진입도로 개설 및 어항 정비 공사가 2027년까지 추진된다.
여수지방해양수산청은...
- 2023-07-05
-
- 전남교육청 '365+체육온활동' 영상 보급
- 전남도교육청이 코로나19 이후 비만 학생이 늘어남에 따라 신체활동을 할 수 있도록 \'365+체육온활동\' 교육을 본격 추진한다.
도교육청은 비만·저체력 학생이 신체활동을 할 수 있도록 \'365+체육온활동 ...
- 2023-07-05

- 서구, 마을로 복지관 MOU 체결
-
광주시 서구는 지난 3일 관내 5개 종합사회복지관과 ‘서구 마을로(路) 복지관’업무협약을 체결했다.
...
- 2023-07-05
-
- 북구, 드론특별자유화구역 재지정…"상용화 실증 나선다"
- 광주 북구가 무인비행체(드론) 특별자유화구역에 재지정되면서 관련 산업 상용화에 앞장선다.
광주 북구는 국토교통부 주관 \'드론특별자유화구역\' 지정 2차 공모에 최종 선정됐다고 4일 밝혔다.
드론...
- 2023-07-05

- 목포해경, 대조기 연안 안전사고 위험예보제 '주의보' 발령
-
목포해양경찰서는 대조기 해안침수 주의정보에 따라 4일부터 7일까지 4일간 목포시, 무안·함평·영광·...
- 2023-07-05

- “늦은 밤 귀갓길 안전 걱정마세요”
-
광주 동구는 여성 안심 귀갓길에 위치한 다세대주택과 공중화장실 41개소의 구형 건물번호판을 ‘태양...
- 2023-07-05

- 광주시, 집중호우 대비 긴급대책 점검회의
-
광주시는 4일 시청 17층 재난안전대책본부 회의실에서 협업부서와 자치구·광주기상청·광주경찰청과 합...
- 2023-07-05
-
- 광주시, 승강기 사고대응 합동훈련
- 광주시는 5일 오후 2시 광주도시철도 1호선 김대중컨벤션센터역(마륵)에서 도시철도공사, 서부소방서, 한국승강기안전공단, 유지관리업체(대명엘리베이터)와 합동으로 ‘2023년 승강기 사고대응 합동훈련...
- 2023-07-05
-
- '하루 2만마리 충돌사'..광주, 조류충돌 저감사업 지원대상 공모
- 광주시는 건축물 유리창과 투명방음벽에 조류가 충돌, 부상·폐사하는 것을 방지하기 위한 조류충돌 저감사업 대상을 모집한다고 4일 밝혔다.
대상은 광주시에서 건축물·투명방음벽을 관리하는 민간 또...
- 2023-07-05

- 광주시교육청 ‘Cool UP! 청렴UP! 캠페인’ 실시
-
광주시교육청이 4일 이정선 교육감을 비롯한 고위공직자가 참여하는 청렴캠페인을 실시했다고 밝혔다.
...
- 2023-07-05

- 서구, 사회적경제기업 전시·박람회 참가 지원
-
광주시 서구는 오는 14일까지 국내 전시·박람회 참가 지원사업에 참여할 사회적경제기업을 모집한다.
...
- 2023-07-05
-
- 소상공인 경영 안정 ‘한몫’…동구형 맞춤 난방비 지원 주목
- 광주 동구는 소상공인의 적극적인 호응에 힘입어 광주 5개 자치구 가운데 최다 접수율을 기록하며 ‘동구형 맞춤 난방비 지원 사업’을 통해 관내 사업장 2930개소에 총 3억9500여만 원을 지원했다고 밝혔다...
- 2023-07-05

- 동구, 인권 존중 문화 확산 ‘찾아가는 인권교육’
-
광주 동구는 지역 사회 내 인권 감수성을 높이고 인권 존중 문화를 확산하기 위해 ‘찾아가는 인권교육...
- 2023-07-05

- 단계별·맞춤형 교육 ‘2023 주민자치학당’ 성료
-
광주 동구는 최근 주민자치회 위원과 사무국장, 주민들을 대상으로 주민자치회 단계별·맞춤형 심화교...
- 2023-07-05
-
- 수능 11월16일 실시…"적정 난이도 출제"
- 올해 대학수학능력시험(수능)은 11월16일 치러지며 원서는 다음달 24일부터 접수한다.
\'킬러문항\' 논란을 의식한 듯 출제 당국은 \"학교 교육을 충실히 받고 EBS 연계 교재와 강의로 보완하면 풀 수 있도...
- 2023-07-04
- 전남도, 장마철 축산물 안전 강화…14일까지 특별수거검사
-
전남도동물위생시험소는 고온다습한 장마철을 맞아 축산식품 안전관리 강화에 나선다.
전남도동물위...
- 2023-07-04

- 다친 친구위해 항쟁 참여 김영호씨, 이달의 5·18 유공자
-
국립5·18민주묘지관리사무소는 7월의 5·18민주유공자로 고(故) 김영호씨를 선정했다고 3일 밝혔다.
1960...
- 2023-07-04